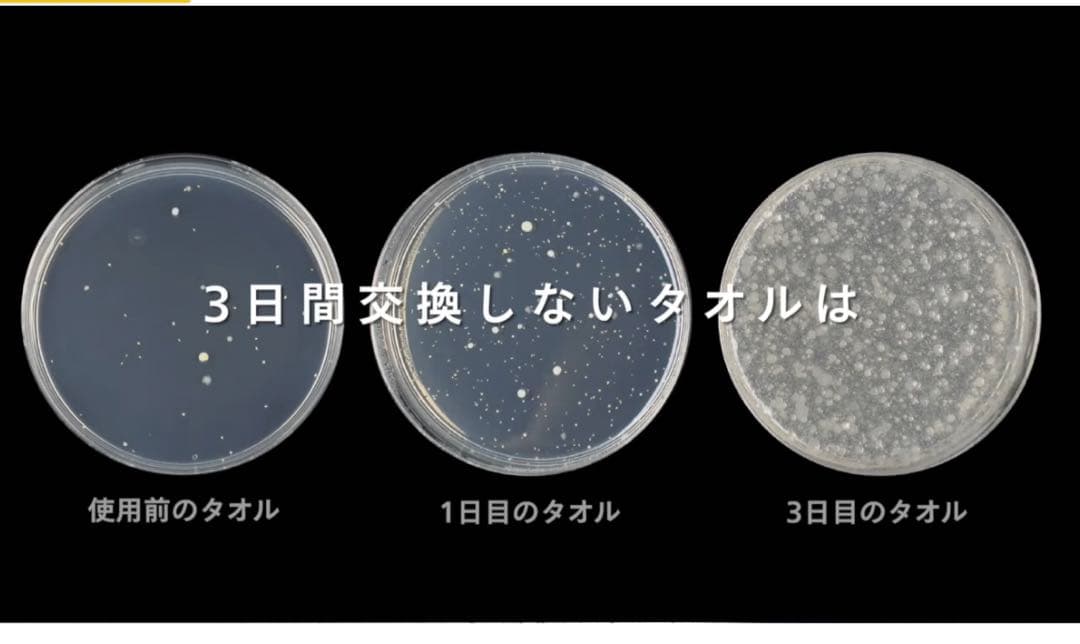
あい⭐︎ecod 自宅やお店に家庭用ハンドドライヤー

マイストア
変更
お店で受け取る
(送料無料)
配送する
納期目安:
2026.03.17 0:0頃のお届け予定です。
決済方法が、クレジット、代金引換の場合に限ります。その他の決済方法の場合はこちらをご確認ください。
※土・日・祝日の注文の場合や在庫状況によって、商品のお届けにお時間をいただく場合がございます。
あい⭐︎ecod 自宅やお店に家庭用ハンドドライヤーの詳細情報
購入定価¥22000-マンションに設置しようと購入しましたが使いたい場所に置けなかったので出品します。ほぼ未使用品 箱も全部揃ってます風圧と温風でパワフル速乾!ペーパータオル不要で経済的にも環境的にもエコ!工事不要!どこでも簡単に設置でき、ご自宅が高級デパートやラウンジ気分!【どこでも使えるコンパクト設計】最新の家庭用小型ハンドドライヤーは、ワンルームのアパートや賃貸マンションでも工事不要で、すぐに設置してご使用できます。家族全員の手洗い後も、待ち時間なしで快適に使用できます。特に小さなお子様や高齢者のいる家庭で、安全に使えるのが魅力です。紙ペーパーの使用も削減でき、環境にもお財布にも優しい選択です。家庭用小型ハンドドライヤーで、毎日の手洗いをより快適に、よりスマートにお過ごしいただけます。【手洗い感染防止 】夏に向けて増える溶連菌感染症&手足口病&新型コロナの感染拡大、手洗いは流水と石けんで十分に行う。 製品仕様品名:ハンドドライヤー【 ecod (エコド) 】品番:SY-157定格電圧:AC100V定格周波数:50/60Hz消費電力:700W本体サイズ(mm):約200(幅) x 約145(奥行き) x 約90(高さ) [壁面設置時]約200(幅) x 約161(奥行き) x 約267(高さ) [スタンド使用時]本体重量:約800g[スタンドなし]約1210g[スタンドあり]カラ−:シルバー, ブラック電源コード:1.6m。その他 Panasonic ziaino。動作確認済です。その他 DL-WH40。パロマ都市ガスFH-E2421SAWLガスふろ給湯器リモコン1セット。【高速乾燥で時短】3秒で45度の温風を生成し、速乾性能で手を素早く乾かします。SINGER 最新型コンピュータミシン SN777αIII 超美品。[値下げ]ハローキティー 限定ミシン。【衛生的で清潔】タオルを使わないため、菌の移動を防ぎ、常に清潔な手を保てます。Oo.ha様 ご依頼 黒森峰 マウス。パナソニック 食器洗い乾燥機 NP-TZ300。【省エネ設計で環境に優しい】手を離すと1秒で自動停止する省エネ設計で、無駄な電力消費を防ぎます。カラーA4複合機 ECOSYS M6635cidn 新品未使用。堀こたつのリモコン。【設置場所】トイレや洗面所だけでなく、キッチンや玄関など、家庭内の様々な場所で活躍します。SBです。刺繍 文字 厚地 ジャノメ ミシン 本体 ハンドメイド 手芸 マスク 洋裁。清潔で快適な生活をサポートするこの小型ハンドドライヤーは、現代の家庭にぴったりのアイテムです。TOTOハンドドライヤーTYC 420w。バング&オルフセン Bang&Olfsen ベオコム Beocom1000。 また、タオルの共用はしてはいけません。リクシル小型電気温水器 200v ゆプラス
ベストセラーランキングです
近くの売り場の商品
カスタマーレビュー
オススメ度 4.9点
現在、4019件のレビューが投稿されています。